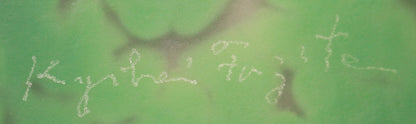
26030　藤田喬平　手吹飾筥　若竹　FUJITA Kyohei

1
/
の
10
商品番号: SKU:26030
26030 藤田喬平 手吹飾筥 若竹 FUJITA Kyohei
26030 藤田喬平 手吹飾筥 若竹 FUJITA Kyohei
販売価格:ASK(お問い合わせください)
通常価格
セール価格
¥0
単価
/
あたり
受取状況を読み込めませんでした
1 People are currently viewing this product



【関連カテゴリ】
Share

辺 14.0cm
芸術家としての最高栄誉である文化勲章を受章し、ガラス工芸の世界を“芸術”へと押し上げた世界的なガラス芸術作家 藤田喬平(1921-2004)本人作。 世界的に大絶賛された、孤高のガラス芸術「飾筥」。しかも本作は、常に人々を魅了し続ける、人気の『若竹』です。 琳派の華麗なる美に私淑し続けた作者が、現代味溢れるガラス芸術で再現した、とても秀逸な作品です。
緑色を軸とした色彩の構成は実に清涼感にみち、豪華絢爛かつ艶美な金銀箔を効果的に装飾し「琳派」の伝統的な美意識を見事に表現しています。 たっぷりとした金箔と銀箔で豪華絢爛なる装飾を施した、最高峰の出来栄えを魅せております。 作者は江戸時代に俵屋宗達や尾形光琳が創造した美の世界に陶酔し、ガラス芸術の世界に「琳派」を導いた張本人であり、本作にも琳派の華やかで妖艶な世界観が内包されています。 まさに世界に「日本の美」を誇らしく掲げる作品と言えましょう。少し工夫して飾ると御家庭でも手軽に幻想的な雰囲気を楽しむことができます。